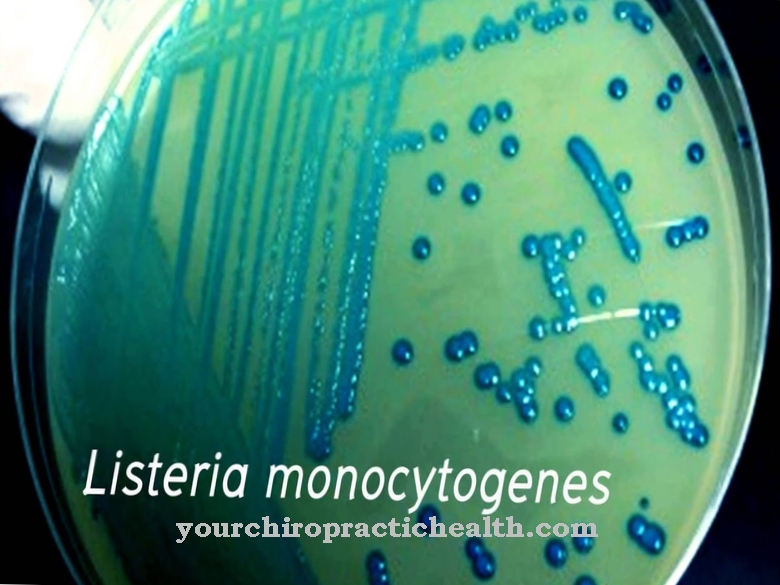

Листерия где
Какой вкус растительного масла
Академус гриль парк фото
7квт 220в какой
Лаби дай
Современные ит это
Мелодии ласковый май
Кофта с кожаными штанами
Состав числа 6 карточка домики
Форум как получить квартиру
Спинной мозг образован клетками ткани
Шоссе энтузиастов 11 1
Кашкирлар 67 кисм узбек тилида
Макет как его сделать
Листерия где 110 фотографий